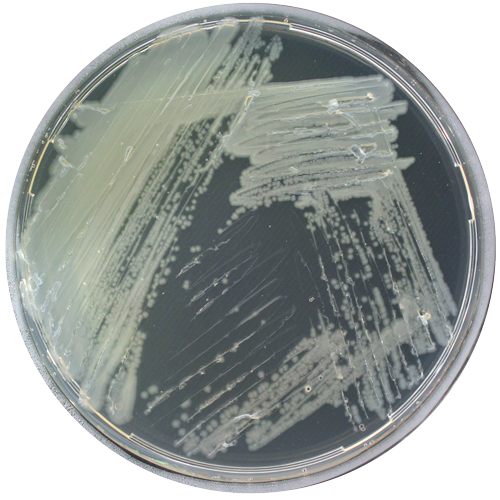

$97.298 más I.V.A.
RGM 3353
Categoría:
Género:
Pseudomonas
Especie:
syringae pv. syringae
Cepa tipo:
No
Código de otra colección:
A1M3 = PSEC-1
Fecha de aislamiento:
2018-11-28
País de origen:
Chile
Historial de deposito:
Instituto de Investigaciones Agropecuarias (INIA)
Sustrato de origen:
Planta (Hojas de cerezo con síntomas; sin información de la variedad)
Acceso GenBank:
JAKLWZ000000000
Temperatura óptima de crecimiento:
25º
Regiónalizas secuenciada:
rpoD
Medio de cultivo:
King B
Nivel de riesgo:
Restricciones de distribución:
Sin restricción de distribución
Información adicional:
Cepa resistente al cobre MIC >0,8 mM (https://biblioteca.inia.cl/bitstream/handle/20.500.14001/6886/Bolet%C3%ADn%20N°%20420?sequence=1&isAllowed=y; http://dx.doi.org/10.4067/S0718-58392021000300378)
Fecha de subida al catálogo:
Secuencias nucleotídicas:
Otros comentarios: